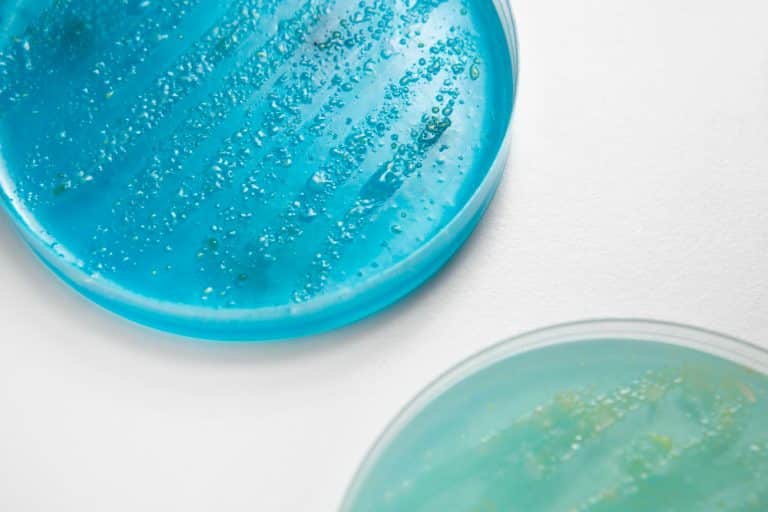

En iyi deneyimleri sunmak için, cihaz bilgilerini saklamak ve/veya bunlara erişmek amacıyla çerezler gibi teknolojiler kullanıyoruz. Bu teknolojilere izin vermek, bu sitedeki tarama davranışı veya benzersiz kimlikler gibi verileri işlememize izin verecektir. Onay vermemek veya onayı geri çekmek, belirli özellikleri ve işlevleri olumsuz etkileyebilir.
Teknik depolama veya erişim, abone veya kullanıcı tarafından açıkça talep edilen belirli bir hizmetin kullanılmasını sağlamak veya bir elektronik iletişim ağı üzerinden bir iletişimin iletimini gerçekleştirmek amacıyla meşru bir amaç için kesinlikle gereklidir.
Teknik depolama veya erişim, abone veya kullanıcı tarafından talep edilmeyen tercihlerin saklanmasının meşru amacı için gereklidir.
Sadece istatistiksel amaçlar için kullanılan teknik depolama veya erişim.
Sadece anonim istatistiksel amaçlar için kullanılan teknik depolama veya erişim. Mahkeme celbi, İnternet Hizmet Sağlayıcınızın gönüllü uyumu veya üçüncü bir taraftan ek kayıtlar olmadan, yalnızca bu amaçla saklanan veya alınan bilgiler genellikle kimliğinizi belirlemek için kullanılamaz.
Teknik depolama veya erişim, reklam göndermek için kullanıcı profilleri oluşturmak veya benzer pazarlama amaçları için kullanıcıyı bir web sitesinde veya birkaç web sitesinde izlemek için gereklidir.